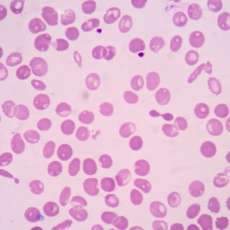
Talasemias

Las talasemias son trastornos hereditarios que se caracterizan por una reducción en la síntesis de las cadenas de globina, que puede afectar a las cadenas alfa o beta, dependiendo del tipo específico de talasemia. La globina es una proteína esencial en la estructura de la hemoglobina, la cual es responsable del transporte de oxígeno en la sangre. Cuando la síntesis de estas cadenas de globina se ve reducida, se genera una disminución en la producción de hemoglobina total. Esta alteración provoca una anemia hipocrómica microcítica, debido a que los glóbulos rojos (eritrocitos) no contienen suficiente hemoglobina, lo que afecta su capacidad para transportar oxígeno.
Las talasemias pueden clasificarse dentro de varios grupos de anemias, ya que involucran mecanismos patofisiológicos complejos. En primer lugar, se consideran anemias hipoproliferativas debido a que, aunque la médula ósea intenta producir glóbulos rojos en respuesta a la anemia, la capacidad de proliferación celular está comprometida por la disfunción en la síntesis de hemoglobina. Además, las talasemias pueden ser vistas como anemias hemolíticas, ya que la producción de glóbulos rojos defectuosos en la médula ósea lleva a un aumento de la destrucción de estas células en la circulación, lo que contribuye a la reducción general de los niveles de hemoglobina en la sangre.
Desde el punto de vista de la patología de la hemoglobina, las talasemias también se consideran un tipo de anemia relacionada con hemoglobinas anormales, ya que la globina defectuosa afecta la estructura de la hemoglobina, lo que a su vez impide su funcionamiento adecuado. Esta anormalidad en la hemoglobina se asocia con alteraciones en la morfología de los glóbulos rojos, los cuales se vuelven más pequeños (microcíticos) y pálidos (hipocrómicos). Estos cambios en la morfología son los hallazgos más característicos de las talasemias en los análisis de sangre, donde se observa una disminución en el volumen corpuscular medio (MCV) y la hemoglobina corpuscular media (MCH), ambos indicadores de una menor cantidad de hemoglobina en los glóbulos rojos.
Una de las características clave de las talasemias es la producción de un número elevado de glóbulos rojos pequeños y pálidos, lo que se refleja en un recuento de glóbulos rojos normal o incluso elevado en el hemograma. Este aumento en el recuento de glóbulos rojos ocurre porque la médula ósea está hiperactiva, intentando compensar la destrucción prematura de los glóbulos rojos defectuosos. Sin embargo, a pesar de esta proliferación de glóbulos rojos, la médula ósea no es capaz de producir suficientes células sanguíneas funcionales debido a la insuficiente hemoglobina. Esto significa que, a pesar de la producción aumentada de glóbulos rojos, el paciente sigue presentando anemia.
El recuento elevado de reticulocitos, que son glóbulos rojos inmaduros, es otro hallazgo frecuente en los pacientes con talasemia. Esto refleja un intento de la médula ósea por compensar la destrucción de los glóbulos rojos maduros. Sin embargo, aunque la producción de reticulocitos aumenta, esta respuesta generalmente no es suficiente para contrarrestar la destrucción acelerada de los glóbulos rojos en la circulación. Por lo tanto, los pacientes con talasemia siguen estando anémicos, ya que la tasa de destrucción de los glóbulos rojos supera la capacidad de producción de nuevos eritrocitos.
La hemoglobina normal en adultos está compuesta principalmente por hemoglobina A, que representa aproximadamente el 98% de la hemoglobina circulante. La hemoglobina A es un tetrámero formado por dos cadenas de globina alfa y dos cadenas de globina beta, lo que se denota como la estructura α₂β₂. Este tetrámero es la forma funcional predominante de hemoglobina en la circulación sanguínea de los adultos, y es crucial para el transporte de oxígeno desde los pulmones a los tejidos periféricos.
En términos genéticos, las dos copias del gen que codifican las cadenas de globina alfa se encuentran en cada uno de los cromosomas 16. La globina alfa es esencial en la formación de hemoglobina en los adultos, y no existe un sustituto para la cadena alfa en la estructura de la hemoglobina adulta. Por otro lado, el gen de la globina beta se localiza en cada cromosoma 11, adyacente a otros genes que codifican para globinas beta-like, como la globina delta y la globina gamma, dentro de una región conocida como el «conjunto de genes de la globina beta». Esta organización génica facilita la regulación de la producción de las diferentes cadenas de globina en diferentes etapas del desarrollo.
Además de la hemoglobina A, existe una pequeña proporción de otras formas de hemoglobina en el adulto normal. Una de ellas es la hemoglobina A2, que se forma por la asociación de dos cadenas de globina alfa y dos cadenas de globina delta, lo que da lugar al tetrámero α₂δ₂. La hemoglobina A2 constituye normalmente entre el 1% y el 3% de la hemoglobina en los adultos.
Otra forma de hemoglobina presente en pequeñas cantidades en los adultos es la hemoglobina F, que se encuentra principalmente durante el desarrollo fetal. La hemoglobina F está formada por un tetrámero de dos cadenas de globina alfa y dos cadenas de globina gamma (α₂γ₂). Durante la vida fetal, la hemoglobina F es la principal responsable del transporte de oxígeno. Sin embargo, en los adultos normales, la hemoglobina F está presente en menos del 1% de la hemoglobina total, ya que su producción disminuye considerablemente después del nacimiento.
La transición entre la producción de hemoglobina F y hemoglobina A es un proceso clave en el desarrollo humano, y su alteración puede estar relacionada con ciertos trastornos hematológicos, como las talasemias o las hemoglobinopatías. La variabilidad en la expresión de estas diferentes formas de hemoglobina depende de la regulación genética de los genes de la globina, lo que se ve afectado en enfermedades hereditarias de la hemoglobina.
Las talasemias se clasifican en tres formas principales según la gravedad clínica y los hallazgos laboratoriales. Estas categorías son rasgo talasémico, talasemia intermedia y talasemia mayor, y se distinguen principalmente por el impacto clínico de la enfermedad y la necesidad de tratamiento.
- Rasgo talasémico: Esta forma es la menos grave y generalmente no presenta síntomas clínicos significativos. En los individuos con rasgo talasémico, se observan características laboratoriales típicas de la talasemia, como la anemia microcítica e hipocrómica, sin embargo, la condición no afecta de manera significativa la salud o la calidad de vida del paciente. Las personas con rasgo talasémico pueden llevar una vida normal, aunque pueden tener un leve déficit en la capacidad de transportar oxígeno debido a la menor cantidad de hemoglobina funcional en sus glóbulos rojos. El diagnóstico generalmente se realiza a través de análisis de sangre que revelan niveles bajos de hemoglobina y un volumen corpuscular medio (MCV) reducido, pero sin requerir tratamiento o intervención médica significativa.
- Talasemia intermedia: En este caso, los pacientes experimentan una forma moderada de la enfermedad, con síntomas que pueden incluir anemia de grado leve a moderado y, en algunos casos, la necesidad ocasional de transfusiones de glóbulos rojos para corregir la anemia. Aunque no es una enfermedad completamente debilitante, la talasemia intermedia puede tener un impacto significativo en la calidad de vida, dependiendo de la gravedad de la anemia y las complicaciones asociadas. Estos pacientes pueden desarrollar otros problemas relacionados con la enfermedad, como el agrandamiento del bazo (esplenomegalia) o el hígado (hepatomegalia), y pueden requerir tratamiento en ciertas circunstancias, pero generalmente no son dependientes de transfusiones regulares.
- Talasemia mayor: Esta es la forma más grave de la enfermedad y se caracteriza por ser potencialmente mortal. Los pacientes con talasemia mayor suelen ser dependientes de transfusiones periódicas de glóbulos rojos para mantener niveles adecuados de hemoglobina, ya que la producción de hemoglobina funcional en su cuerpo es muy limitada. Sin tratamiento adecuado, la talasemia mayor puede llevar a una serie de complicaciones graves, que incluyen insuficiencia orgánica y problemas relacionados con el crecimiento y el desarrollo. Uno de los mayores desafíos en el manejo de la talasemia mayor es el exceso de hierro que se acumula en el organismo debido a las transfusiones repetidas. A medida que los glóbulos rojos transfundidos se destruyen en el cuerpo, el hierro liberado no se puede eliminar de manera eficiente, lo que conduce a una sobrecarga de hierro en órganos vitales como el corazón, el hígado y el páncreas. Aunque la terapia de quelación de hierro ha mejorado significativamente el pronóstico de los pacientes, la sobrecarga de hierro sigue siendo una de las principales causas de muerte en pacientes con talasemia mayor, incluso con los tratamientos modernos.
La alfa-talasemia es un trastorno causado principalmente por deleciones génicas que reducen la síntesis de las cadenas de globina alfa. Como la globina alfa es un componente esencial de todas las formas de hemoglobina adulta, una disminución en su producción tiene un impacto directo en la cantidad de hemoglobina funcional disponible en la sangre. En condiciones normales, cada gen alfa-globina produce un cuarto de la cantidad total de globina alfa necesaria para formar hemoglobina. Por lo tanto, la pérdida de un gen alfa-globina causa una disminución proporcional en la cantidad de globina alfa producida, y esta reducción sigue un patrón predecible en relación con la cantidad de genes alfa perdidos.
La alfa-talasemia puede manifestarse de diferentes maneras según el número de genes alfa que se vean afectados. En su forma más leve, cuando se pierde solo un gen alfa, el individuo puede ser portador del rasgo talasémico alfa, sin presentar síntomas clínicos graves. En casos más graves, cuando se pierden dos o más genes alfa, los síntomas pueden ser más evidentes y la condición puede ser lo suficientemente severa como para requerir transfusiones de glóbulos rojos o provocar complicaciones hematológicas más serias.
Una característica importante de la alfa-talasemia es que, debido a que todas las hemoglobinas adultas contienen cadenas de globina alfa, la proporción de hemoglobinas A, A2 y F en el electroforesis de hemoglobina no cambia significativamente. Esto significa que, aunque haya una disminución en la cantidad de globina alfa, las proporciones de estas hemoglobinas no se ven alteradas, lo que puede hacer que la alfa-talasemia no sea fácil de diagnosticar solo a partir del análisis de hemoglobina, sin considerar otros aspectos clínicos y laboratoriales.
En las formas más graves de la alfa-talasemia, especialmente cuando faltan tres o los cuatro genes alfa-globina, la insuficiencia de las cadenas alfa puede dar lugar a la acumulación de cadenas de globina beta. En este contexto, las cadenas beta pueden unirse para formar un tetrámero de hemoglobina conocido como hemoglobina H (HbH), que consiste en cuatro cadenas beta (β₄). La formación de hemoglobina H es una respuesta compensatoria a la falta de cadenas alfa, pero esta hemoglobina tiene varias características problemáticas.
La hemoglobina H es inestable y tiene una tendencia a precipitarse dentro de los glóbulos rojos. La acumulación de estos complejos de cadenas beta no solo disminuye la eficiencia de transporte de oxígeno, sino que también causa daño a las membranas de los glóbulos rojos. Esta precipitación de hemoglobina H dentro de los glóbulos rojos lleva a su destrucción prematura, un proceso conocido como hemólisis. La hemólisis puede ocurrir tanto dentro de la médula ósea (hemólisis intramedular) como en la circulación periférica (hemólisis periférica), lo que contribuye a la anemia característica de la alfa-talasemia grave.
El daño a los glóbulos rojos debido a la hemoglobina H y la hemólisis resultante pueden generar una serie de problemas clínicos. La anemia causada por la destrucción acelerada de los glóbulos rojos puede ser severa, y los pacientes pueden presentar síntomas como fatiga, palidez, esplenomegalia (agrandamiento del bazo) e ictericia. Además, la sobrecarga de hierro debido a la transfusión de glóbulos rojos puede ser un problema adicional en los pacientes con alfa-talasemia grave.
La beta-talasemia es un trastorno genético que generalmente resulta de mutaciones puntuales en lugar de deleciones, lo que implica una alteración en la secuencia de los nucleótidos de los genes que codifican para la cadena de globina beta. Estas mutaciones pueden dar lugar a terminación prematura de la cadena o a problemas en la transcripción del ARN, lo que finalmente resulta en una reducción o ausencia de la síntesis de la cadena de globina beta. Las mutaciones causantes de la beta-talasemia son muy diversas y heterogéneas, lo que significa que hay una gran variabilidad en los tipos de defectos moleculares asociados con la enfermedad.
Existen dos tipos principales de mutaciones en beta-talasemia:
- Beta⁰ (beta-cero): Estas mutaciones causan la ausencia total de la síntesis de globina beta. Los pacientes con beta⁰-talasemia no producen ninguna cantidad funcional de globina beta.
- Beta⁺ (beta-plus): En este caso, las mutaciones resultan en una síntesis reducida de globina beta, pero no completamente ausente. La cantidad de globina beta producida es menor de lo normal, lo que da lugar a una deficiencia de hemoglobina A (α₂β₂). La cantidad de reducción en la producción de globina beta varía considerablemente entre familias, pero dentro de una misma familia suele ser consistente.
La reducción en la síntesis de globina beta tiene varias consecuencias a nivel sanguíneo. Como la globina beta es una parte esencial de la hemoglobina A, su disminución provoca un cambio en la proporción de las distintas formas de hemoglobina en la sangre. En lugar de la hemoglobina A (α₂β₂), se observa un aumento relativo en las proporciones de hemoglobina A2 (α₂δ₂) y hemoglobina F (α₂γ₂), ya que las cadenas de globina delta y gamma (de la familia de globinas beta-like) sustituyen a las cadenas beta faltantes. Este cambio es detectable en el electroforesis de hemoglobina, donde la hemoglobina A estará reducida y habrá un incremento en los niveles de hemoglobina A2 y F.
Además de la alteración en la hemoglobina, la falta de globina beta provoca un exceso relativo de cadenas de globina alfa. Las cadenas alfa son inestables en ausencia de una cantidad adecuada de globina beta y, por lo tanto, precipitan dentro de los glóbulos rojos. Esta precipitación daña las membranas de los glóbulos rojos, lo que provoca su destrucción prematura, o hemólisis. La hemólisis puede ocurrir tanto dentro de la médula ósea (hemólisis intramedular) como en la circulación periférica (hemólisis periférica), lo que contribuye a la anemia característica de la beta-talasemia.
La médula ósea responde a la anemia crónica produciendo un número elevado de células eritroides, lo que lleva a un fenómeno conocido como hiperplasia eritroide. Sin embargo, debido a la eritropoyesis inefectiva (la producción de glóbulos rojos defectuosos que no maduran correctamente), los glóbulos rojos no son funcionales y se destruyen dentro de la médula. Esto aumenta la carga de trabajo de la médula ósea, que intenta compensar la falta de glóbulos rojos maduros.
En los casos más graves de beta-talasemia, la expansión significativa del compartimento eritroide en la médula ósea puede llevar a deformidades óseas graves, osteopenia (pérdida de densidad ósea) y fracturas óseas patológicas. Además, el cuerpo puede intentar generar células sanguíneas fuera de la médula ósea, un fenómeno denominado hematopoyesis extramedular. Esta hematopoyesis extramedular se puede observar en órganos como el bazo y el hígado, lo que puede dar lugar a esplenomegalia (agrandamiento del bazo) y hepatomegalia (agrandamiento del hígado).
Manifestaciones clínicas
Los síndromes de alfa-talasemia son trastornos hereditarios que afectan principalmente a personas de Asia sudoriental y China, aunque también se observan, con menor frecuencia, en personas de origen africano y mediterráneo. La alfa-talasemia está relacionada con la reducción o ausencia de la síntesis de las cadenas de globina alfa, y su gravedad depende del número de genes alfa-globina afectados.
En condiciones normales, los adultos poseen cuatro copias del gen alfa-globina, distribuidas en los cromosomas 16. La presencia de tres genes alfa-globina generalmente no produce efectos clínicos, y el paciente se considera un portador silente de la alfa-talasemia, sin evidencia de anemia o síntomas hematológicos.
A medida que se pierden más genes alfa-globina, la gravedad del trastorno aumenta. Las principales formas clínicas de alfa-talasemia incluyen:
- Rasgo alfa-talasemia (alfa-talasemia menor): En esta forma, el paciente tiene dos genes alfa-globina (uno de ellos afectado), lo que da lugar a una síntesis reducida de globina alfa. Dependiendo de la población afectada, la forma del trastorno varía:
- Alfa-talasemia-1 (forma más común en personas de ascendencia asiática): La deleción heterocigota del gen alfa (α⁻/α⁻) da lugar a una ligera disminución en la producción de globina alfa, pero generalmente no presenta síntomas clínicos significativos. Los pacientes son hematológicamente normales, con una ligera anemia microcítica. Su esperanza de vida y calidad de vida son normales.
- Alfa-talasemia-2 (más común en personas de origen africano): La deleción homocigota del gen alfa (αα/––) también produce una síntesis reducida de globina alfa, pero los pacientes permanecen clínicamente normales, aunque pueden presentar una anemia leve.
- Enfermedad de hemoglobina H (alfa-talasemia-3): Esta forma ocurre cuando solo queda un gen alfa-globina (α⁻/––). En este caso, la insuficiencia de cadenas alfa es lo suficientemente grave como para que se forme hemoglobina H, que es un tetrámero compuesto solo por cadenas beta (β₄). La hemoglobina H es inestable y tiende a precipitar, lo que daña los glóbulos rojos y provoca una anemia hemolítica crónica de gravedad variable. Los pacientes con enfermedad de hemoglobina H pueden ser clasificados como talasemia menor o intermedia, dependiendo de la severidad de la anemia. A menudo, presentan palidez y esplenomegalia (agrandamiento del bazo). En general, no requieren transfusiones de manera regular, pero estas pueden ser necesarias durante exacerbaciones hemolíticas transitorias, causadas por infecciones u otros factores estresantes, o en casos de crisis aplástica, una condición asociada con ciertas infecciones virales que inhiben temporalmente la producción de glóbulos rojos.
- Hidrops fetalis: La forma más grave de alfa-talasemia ocurre cuando los cuatro genes alfa-globina están eliminados. En este caso, no se produce hemoglobina normal (ni hemoglobina A ni hemoglobina A2), y el feto afectado desarrolla una condición conocida como hidrops fetalis, que es una forma letal de insuficiencia cardíaca fetal y edema generalizado. El único tipo de hemoglobina que se produce en este contexto es hemoglobina Bart’s (γ₄), que está compuesta únicamente por cadenas gamma. La hemoglobina Bart’s no es funcional para el transporte de oxígeno, y debido a la completa ausencia de hemoglobina normal, el feto no sobrevive al parto, resultando en un nacimiento muerto.
La beta-talasemia es una enfermedad hereditaria que afecta principalmente a personas de origen mediterráneo (como italianos y griegos), aunque también puede encontrarse, en menor medida, en personas de ascendencia asiática y africana. Esta condición se debe a mutaciones en el gen de la globina beta, que resultan en una producción reducida o ausente de la cadena beta de la hemoglobina. Existen dos tipos principales de beta-talasemia: beta⁰-talasemia (sin producción de globina beta) y beta⁺-talasemia (con producción reducida de globina beta).
Los pacientes homocigotos para beta-talasemia (es decir, aquellos que tienen dos copias del gen mutado, como beta⁰/beta⁰ o algunos con beta⁺/beta⁺) presentan beta-talasemia mayor o anemia de Cooley, la forma más grave de la enfermedad. Los niños nacen normales, con una cantidad suficiente de hemoglobina fetal (hemoglobina F), que es la forma predominante de hemoglobina en la vida fetal. Sin embargo, después de los 6 meses de vida, cuando la transición de la hemoglobina fetal a la hemoglobina adulta (hemoglobina A) ocurre, se desarrolla una anemia severa debido a la insuficiente producción de hemoglobina A. Esta anemia a menudo requiere transfusiones de glóbulos rojos para mantener niveles adecuados de hemoglobina.
A medida que progresa la enfermedad, surgen numerosos problemas clínicos:
- Retraso en el crecimiento: Los pacientes pueden experimentar un crecimiento anómalo y una baja talla debido a la anemia crónica y la hipoxia.
- Deformidades óseas: La expansión de la médula ósea, como respuesta a la eritropoyesis inefectiva, puede provocar deformidades óseas características, especialmente en la estructura facial (característica «en forma de luna» del cráneo) y fracturas óseas patológicas.
- Hepatoesplenomegalia: El bazo y el hígado se agrandan debido a la acumulación de células sanguíneas en la médula ósea y a la destrucción de glóbulos rojos, lo que lleva a la esplenomegalia (agrandamiento del bazo) y hepatomegalia (agrandamiento del hígado).
- Ictericia: La destrucción de glóbulos rojos (hemólisis) genera bilirrubina libre, que se deposita en los tejidos y provoca coloración amarillenta en la piel y los ojos. La ictericia también puede estar asociada con cálculos biliares y cirrosis hepática relacionada con la enfermedad hepática crónica (hepatitis o cirrosis asociada con transfusiones repetidas).
- Trombofilia: Los pacientes con beta-talasemia mayor tienen un mayor riesgo de trastornos de la coagulación, lo que los hace propensos a eventos trombóticos, como coágulos sanguíneos.
Aunque la terapia de transfusiones ha mejorado significativamente la calidad de vida de los pacientes con beta-talasemia mayor, también plantea un problema importante: la sobrecarga de hierro debido a las transfusiones frecuentes. Cada vez que un paciente recibe transfusiones de glóbulos rojos, introduce hierro en su cuerpo, pero el cuerpo humano no tiene un mecanismo activo para eliminar el exceso de hierro. Con el tiempo, el exceso de hierro se acumula en diversos órganos, especialmente en el corazón, hígado y glándulas endocrinas, lo que conduce a una condición llamada hemosiderosis.
La hemosiderosis provoca una serie de complicaciones graves que imitan los síntomas de hemocromatosis, una enfermedad en la que el hierro se acumula de manera patológica en los tejidos. Estas complicaciones incluyen:
- Fallo cardíaco (HF): La acumulación de hierro en el corazón puede dañar el músculo cardíaco, causando insuficiencia cardíaca.
- Arritmias cardíacas: El daño al corazón también puede provocar irregularidades en el ritmo cardíaco.
- Cirrosis hepática: El exceso de hierro en el hígado puede llevar a la cirrosis, una condición que impide que el hígado funcione adecuadamente.
- Endocrinopatías: El exceso de hierro afecta las glándulas endocrinas, causando trastornos hormonales como diabetes, hipotiroidismo o problemas en las glándulas reproductivas.
- Pseudoxantoma elástico: Esta es una complicación rara pero característica, que involucra la calcificación y fragmentación de las fibras elásticas en la piel, la retina y el sistema cardiovascular, lo que puede causar problemas dermatológicos y vasculares.
Antes de que existieran tratamientos más efectivos como el trasplante de células madre alogénicas y los tratamientos de quelación de hierro (para eliminar el exceso de hierro del cuerpo), los pacientes con beta-talasemia mayor solían morir debido a las complicaciones de la sobrecarga de hierro, generalmente entre los 20 y 30 años de edad. La terapia de quelación de hierro, que ayuda a prevenir la toxicidad por hierro, ha prolongado la vida de los pacientes significativamente.
La beta-talasemia intermedia es una forma moderada de beta-talasemia que generalmente ocurre en pacientes homocigotos para una forma más leve de beta-talasemia, es decir, aquellos con genotipos beta⁺/beta⁺. En estos pacientes, aunque la síntesis de la globina beta sigue siendo reducida en comparación con individuos normales, la capacidad de producción de hemoglobina es suficiente para evitar la gravedad de la beta-talasemia mayor (anemia de Cooley). Sin embargo, la producción de globina beta no es completamente normal, lo que lleva a una anemia hemolítica crónica de intensidad moderada, pero no tan severa como en los casos más graves.
A pesar de que los pacientes con beta-talasemia intermedia tienen anemia crónica, generalmente no requieren transfusiones regulares. Las transfusiones solo son necesarias en periodos de estrés, como durante infecciones o situaciones que aumentan la demanda de glóbulos rojos, o en casos de crisis aplástica, que es una reducción temporal de la producción de glóbulos rojos, a menudo provocada por infecciones virales. Durante estos episodios, la anemia puede agravarse temporalmente, y las transfusiones pueden ser necesarias para estabilizar la condición del paciente.
No obstante, la necesidad ocasional de transfusiones puede llevar al desarrollo de sobrecarga de hierro en algunos pacientes, ya que el exceso de hierro no se elimina eficazmente del cuerpo y se acumula en órganos vitales como el corazón, hígado y glándulas endocrinas, similar a lo que ocurre en la beta-talasemia mayor. A pesar de la sobrecarga de hierro, los pacientes con beta-talasemia intermedia pueden sobrevivir hasta la edad adulta. Sin embargo, a lo largo de su vida, suelen desarrollar hepatosplenomegalia (agrandamiento del hígado y bazo) y deformidades óseas debido a la expansión de la médula ósea y la destrucción continua de glóbulos rojos.
En el caso de los pacientes heterocigotos para beta-talasemia (es decir, aquellos con el genotipo beta/ beta⁰ o beta/ beta⁺), se observa lo que se conoce como beta-talasemia menor, una forma más leve de la enfermedad. Estos pacientes tienen una anemia microcítica que, aunque se detecta en análisis de sangre, es clínicamente insignificante. Generalmente, no presentan síntomas graves y no requieren tratamiento, ya que la cantidad de globina beta producida es suficiente para mantener una función hematológica relativamente normal.
Para las familias en riesgo, se ofrece la opción de diagnóstico prenatal, lo cual permite detectar la presencia de la beta-talasemia antes del nacimiento. Además, el asesoramiento genético es esencial para informar a las familias sobre el riesgo de transmisión de la enfermedad y las opciones disponibles para el manejo. El diagnóstico prenatal puede incluir técnicas como la amniocentesis o biopsia de vellosidades coriónicas para detectar mutaciones en los genes que codifican para la globina beta.
Hallazgos de laboratorio
Rasgo de alfa-talasemia
El rasgo de alfa-talasemia es una forma más leve de la enfermedad, que generalmente no produce síntomas clínicos graves. Los pacientes con este rasgo pueden tener una anemia leve o no tener anemia significativa en absoluto. Los hallazgos de laboratorio asociados con el rasgo de alfa-talasemia incluyen:
- Hemoglobina y hematocrito:
- Los pacientes suelen tener hematocritos en el rango de 28% a 40%, lo que indica una anemia leve o ausente. Sin embargo, este rango de hematocrito refleja una cantidad de glóbulos rojos relativamente normal, lo que sugiere que la anemia es generalmente leve o subclínica.
- Volumen corpuscular medio (MCV):
- El MCV (volumen corpuscular medio) está significativamente bajo, en el rango de 60–75 fL, a pesar de que la anemia es relativamente leve. Este hallazgo es característico de los trastornos microcíticos, como la alfa-talasemia, donde los glóbulos rojos son más pequeños de lo normal.
- Recuento de glóbulos rojos:
- El número de glóbulos rojos puede estar normal o aumentado. Esto se debe a que, aunque los glóbulos rojos son pequeños, la producción puede ser aumentada como respuesta a la anemia leve. No obstante, no hay una destrucción excesiva de glóbulos rojos que justifique un recuento extremadamente alto.
- Frotis sanguíneo periférico:
- El frotis de sangre periférica muestra varias características típicas de los trastornos de la hemoglobina, como:
- Microcitos (glóbulos rojos más pequeños de lo normal).
- Hipocromía (glóbulos rojos con menor contenido de hemoglobina, lo que les da un color más pálido).
- Células en diana (target cells), que son glóbulos rojos con una estructura central de hemoglobina más densa, que forma un patrón en forma de objetivo.
- Acanocitos (glóbulos rojos con proyecciones espinosas irregulares). Este hallazgo es menos común, pero puede observarse en casos de alfa-talasemia.
- El frotis de sangre periférica muestra varias características típicas de los trastornos de la hemoglobina, como:
- Conteo de reticulocitos:
- El conteo de reticulocitos (glóbulos rojos inmaduros) suele ser normal o levemente aumentado, lo que indica una respuesta compensatoria moderada a la anemia, si es que existe.
- Electroforesis de hemoglobina:
- En la electroforesis de hemoglobina, los resultados son generalmente normales, ya que la producción de hemoglobina A (alfa2beta2) no está significativamente afectada en el rasgo de alfa-talasemia. Esto es importante porque, en los casos más graves de alfa-talasemia, podrían aparecer hemoglobinas anormales (como la hemoglobina H o Bart’s), pero no en el rasgo.
El diagnóstico de rasgo de alfa-talasemia se basa principalmente en la exclusión de otras causas de anemia microcítica, como la deficiencia de hierro. En muchos casos, debido a la ausencia de síntomas clínicos graves, el diagnóstico se hace a través de análisis de sangre que muestran los hallazgos descritos anteriormente. Sin embargo, dado que los resultados de laboratorio no siempre son concluyentes, la prueba genética para detectar la deleción del gen alfa-globina es una herramienta clave para confirmar el diagnóstico. Esta prueba identifica las deleciones en los genes alfa-globina que son responsables de la alfa-talasemia.
Enfermedad de Hemoglobina H (Hemoglobin H Disease)
La enfermedad de hemoglobina H es una forma más grave de alfa-talasemia que ocurre cuando el paciente tiene solo una copia funcional del gen alfa-globina (es decir, tiene una deleción de tres genes alfa-globina). Esto provoca una producción insuficiente de cadenas alfa y un exceso de cadenas beta, lo que da lugar a la formación de hemoglobina H (β₄), una tetramera de cadenas beta. La enfermedad puede variar en gravedad, pero los hallazgos de laboratorio son típicos y reflejan un cuadro de anemia moderada a grave.
- Hemoglobina y hematocrito:
- Los pacientes con hemoglobina H suelen tener una anemia más pronunciada en comparación con los portadores del rasgo de alfa-talasemia. Los hematocritos se encuentran típicamente entre 22% y 32%, lo que indica una anemia moderada a grave.
- Volumen corpuscular medio (MCV):
- El MCV (volumen corpuscular medio) está notablemente bajo, en el rango de 60–70 fL, lo que refleja la microcitosis (glóbulos rojos pequeños) característica de la enfermedad.
- Frotis sanguíneo periférico:
- El frotis sanguíneo periférico muestra una serie de características distintivas:
- Hipocromía: Los glóbulos rojos presentan un color pálido debido a la menor cantidad de hemoglobina.
- Microcitosis: Los glóbulos rojos son más pequeños de lo normal.
- Células en diana (target cells): Estas células presentan una apariencia en forma de objetivo debido a la distribución anómala de hemoglobina en su interior.
- Poiquilocitosis: Los glóbulos rojos tienen formas irregulares, lo que sugiere la inestabilidad estructural de las membranas celulares debido al exceso de cadenas beta y la formación de hemoglobina H.
- El frotis sanguíneo periférico muestra una serie de características distintivas:
- Conteo de reticulocitos:
- El conteo de reticulocitos está elevado. Los reticulocitos son glóbulos rojos inmaduros, y su número elevado refleja la respuesta del cuerpo a la anemia crónica. Aunque la producción de glóbulos rojos es aumentada, la eritropoyesis sigue siendo ineficaz debido a la hemólisis intramedular y periférica, lo que resulta en la destrucción de muchos glóbulos rojos en desarrollo en la médula ósea.
- Recuento de glóbulos rojos (RBC):
- El número total de glóbulos rojos puede estar normal o elevado, ya que, a pesar de la destrucción de los glóbulos rojos, la médula ósea aumenta la producción de glóbulos rojos en un intento de compensar la hemólisis.
- Electroforesis de hemoglobina:
- En la electroforesis de hemoglobina, se observa una hemoglobina anómala, denominada hemoglobina H. Esta hemoglobina tiene una movilidad rápida en el gel de electroforesis, ya que está formada por una tetramera de cuatro cadenas beta (β₄). La hemoglobina H constituye entre el 10% y el 40% de la hemoglobina total del paciente.
- Tinción supravital:
- Para demostrar la presencia de hemoglobina H en el frotis sanguíneo, se pueden usar tintas supravitales, que tiñen los glóbulos rojos en sus etapas inmaduras y revelan la presencia de inclusiones de hemoglobina H dentro de los glóbulos rojos. Estas inclusiones son pequeños corpúsculos de hemoglobina que se acumulan dentro de los glóbulos rojos, debido a la inestabilidad de las tetrameras de hemoglobina H.
Los pacientes con enfermedad de hemoglobina H presentan una anemia crónica moderada a grave, que puede llevar a síntomas como fatiga, pallor, y ocasionalmente esplenomegalia (agrandamiento del bazo) debido a la hemólisis crónica. Aunque no requieren transfusiones de sangre en la mayoría de los casos, las crisis hemolíticas pueden ocurrir durante episodios de estrés, como infecciones o factores desencadenantes, lo que puede requerir tratamiento con transfusiones.
La enfermedad de hemoglobina H está asociada con un riesgo elevado de sobrecarga de hierro debido a la transfusión repetida, lo que puede resultar en daño orgánico si no se maneja adecuadamente.
En cuanto al diagnóstico, la electroforesis de hemoglobina y las pruebas de tinción supravital son cruciales para identificar la presencia de hemoglobina H, mientras que los hallazgos en el frotis sanguíneo proporcionan pistas adicionales sobre la condición. La confirmación genética de la deleción de los genes alfa-globina es útil para diagnosticar de manera definitiva la enfermedad de hemoglobina H.
Beta-talasemia menor (Beta-thalassemia minor)
La beta-talasemia menor es una forma más leve de beta-talasemia, y generalmente no causa síntomas graves. Es el resultado de una mutación en uno de los genes de la globina beta, lo que lleva a una producción reducida de globina beta. En los individuos con beta-talasemia menor, la síntesis de globina beta está disminuida, pero suficiente para evitar una anemia grave, y los pacientes suelen tener una anemia leve. Los hallazgos de laboratorio son clave para el diagnóstico de esta condición.
- Hemoglobina y hematocrito:
- Los pacientes con beta-talasemia menor generalmente tienen un hematocrito entre el 28% y el 40%, lo que refleja una anemia leve. En muchos casos, la anemia es modesta, y los pacientes no suelen presentar síntomas graves relacionados con la reducción en los niveles de hemoglobina.
- Volumen corpuscular medio (MCV):
- El MCV (volumen corpuscular medio) se encuentra en el rango de 55 fL a 75 fL, lo que es característico de una microcitosis (glóbulos rojos más pequeños de lo normal), aunque no tan marcado como en las formas más graves de talasemia. Esta es una característica distintiva de las anemias microcíticas, como la beta-talasemia menor.
- Recuento de glóbulos rojos (RBC):
- El recuento de glóbulos rojos es normal o ligeramente elevado, ya que la médula ósea compensa la reducción en la hemoglobina produciendo más glóbulos rojos. Sin embargo, debido a la ineficaz eritropoyesis, los glóbulos rojos producidos pueden ser más pequeños y menos funcionales.
- Conteo de reticulocitos:
- El conteo de reticulocitos puede ser normal o ligeramente elevado, ya que el cuerpo responde a la anemia leve produciendo un número algo mayor de glóbulos rojos inmaduros, aunque no lo suficiente como para resolver completamente la anemia.
- Frotis sanguíneo periférico:
- El frotis sanguíneo muestra características moderadamente anormales:
- Hipocromía: Los glóbulos rojos tienen una coloración más pálida debido a la reducción en el contenido de hemoglobina.
- Microcitosis: Los glóbulos rojos son más pequeños de lo normal.
- Células en diana (target cells): Estas células tienen una distribución anómala de hemoglobina, lo que les da una apariencia de «objetivo».
- Estippling basofílico: Esta característica es más común en la beta-talasemia menor en comparación con la alfa-talasemia. El estippling basofílico es una apariencia granular o de puntos azules que se observa en los glóbulos rojos debido a la presencia de ribosomas retenidos en su interior, un signo de inmadurez o disfunción en la síntesis de hemoglobina.
- El frotis sanguíneo muestra características moderadamente anormales:
- Electroforesis de hemoglobina:
- En la electroforesis de hemoglobina, se observa un aumento de la hemoglobina A2. La hemoglobina A2 es una forma de hemoglobina formada por dos cadenas alfa y dos cadenas delta (α₂δ₂), y su nivel en individuos con beta-talasemia menor suele estar elevado, generalmente entre 4% y 8% de la hemoglobina total. Esta elevación es un hallazgo característico de la beta-talasemia menor y ocurre debido a la sustitución de las cadenas beta defectuosas por las cadenas delta en la hemoglobina.
- En algunos casos, también puede haber una elevación de hemoglobina F (hemoglobina fetal, α₂γ₂), que puede estar en el rango de 1% a 5% de la hemoglobina total. Esto es porque la producción de hemoglobina fetal (que tiene cadenas gamma en lugar de beta) también puede compensar la reducción de las cadenas beta en la beta-talasemia.
Los pacientes con beta-talasemia menor tienen una anemia leve con un MCV bajo (microcitosis) y un aumento de hemoglobina A2 en la electroforesis de hemoglobina. La hipocromía, microcitosis, células en diana y estippling basofílico en el frotis sanguíneo son hallazgos característicos. Aunque la anemia es leve, el diagnóstico definitivo se realiza con la electroforesis de hemoglobina, que muestra un aumento de hemoglobina A2 y, en algunos casos, hemoglobina F.
El diagnóstico de beta-talasemia menor debe diferenciarse de otras causas de anemia microcítica, como la deficiencia de hierro, mediante pruebas adicionales como los niveles de hierro y la saturación de transferrina. La electroforesis de hemoglobina es esencial para confirmar el diagnóstico, ya que es la única prueba que detecta el aumento de la hemoglobina A2 y proporciona la clave para diferenciarla de otras anemias microcíticas.
Beta-talasemia intermedia (Beta-thalassemia intermedia)
La beta-talasemia intermedia es una forma moderada de beta-talasemia que se caracteriza por una anemia crónica de gravedad intermedia, que no requiere transfusiones de sangre regulares, aunque en algunos casos, los pacientes pueden necesitar transfusiones durante crisis hemolíticas o períodos de estrés. Esta forma de talasemia se presenta cuando los pacientes tienen mutaciones en los dos genes beta-globina que resultan en una síntesis de hemoglobina beta reducida. Sin embargo, a diferencia de la beta-talasemia mayor, en la beta-talasemia intermedia aún hay suficiente producción de hemoglobina para evitar una anemia grave constante, aunque los pacientes sufren de anemia crónica.
- Hemoglobina y hematocrito:
- Los pacientes con beta-talasemia intermedia tienen un hematocrito entre 17% y 33%, lo que refleja una anemia moderada. La severidad de la anemia varía entre los pacientes, pero generalmente es más grave que en la beta-talasemia menor pero menos grave que en la beta-talasemia mayor.
- Volumen corpuscular medio (MCV):
- El MCV (volumen corpuscular medio) varía entre 55 fL y 75 fL, lo que indica una microcitosis (glóbulos rojos pequeños). Este rango es similar al de la beta-talasemia menor, pero la anemia es más pronunciada.
- Recuento de glóbulos rojos (RBC):
- El recuento de glóbulos rojos puede ser normal o elevado, ya que la médula ósea intenta compensar la anemia mediante la producción aumentada de glóbulos rojos. Sin embargo, la eritropoyesis es ineficaz, lo que significa que la médula ósea produce glóbulos rojos defectuosos que son destruidos prematuramente, lo que contribuye a la anemia.
- Conteo de reticulocitos:
- El conteo de reticulocitos está elevado, lo que indica una respuesta aumentada de la médula ósea para compensar la destrucción de glóbulos rojos. Los reticulocitos son glóbulos rojos inmaduros y su número elevado refleja el intento del cuerpo de producir más glóbulos rojos en respuesta a la anemia crónica.
- Frotis sanguíneo periférico:
- El frotis sanguíneo periférico muestra varias características típicas de la beta-talasemia intermedia, incluyendo:
- Hipocromía: Los glóbulos rojos presentan una coloración pálida debido a la reducción de hemoglobina en cada célula.
- Microcitosis: Los glóbulos rojos son más pequeños de lo normal.
- Estippling basofílico: La presencia de gránulos finos en los glóbulos rojos que indican una síntesis defectuosa de hemoglobina.
- Células en diana (target cells): La presencia de células con una apariencia de «objetivo» debido a la distribución anómala de hemoglobina en su interior.
- El frotis sanguíneo periférico muestra varias características típicas de la beta-talasemia intermedia, incluyendo:
- Electroforesis de hemoglobina:
- En la electroforesis de hemoglobina, los hallazgos característicos incluyen:
- Hemoglobina A: Los niveles de hemoglobina A son de hasta el 30% de la hemoglobina total, lo que indica que una cantidad significativa de hemoglobina normal está presente.
- Hemoglobina A2: Los niveles de hemoglobina A2 están elevados hasta un 10%, debido a la producción aumentada de la hemoglobina delta en ausencia de suficientes cadenas beta. Este es un hallazgo común en la beta-talasemia intermedia, ya que las cadenas delta sustituyen parcialmente a las cadenas beta defectuosas.
- Hemoglobina F: Los niveles de hemoglobina F (hemoglobina fetal) están elevados entre 6% y 10%. La hemoglobina F está formada por dos cadenas alfa y dos cadenas gamma, y su producción es más frecuente en individuos con talasemia, como compensación por la deficiencia de cadenas beta.
- En la electroforesis de hemoglobina, los hallazgos característicos incluyen:
Los pacientes con beta-talasemia intermedia presentan una anemia crónica moderada, con MCV bajo y un frotis sanguíneo que muestra hipocromía, microcitosis, estippling basofílico y células en diana. En la electroforesis de hemoglobina, los niveles de hemoglobina A2 pueden estar elevados hasta un 10%, y hemoglobina F puede estar entre el 6% y 10% de la hemoglobina total. Aunque los pacientes con beta-talasemia intermedia no suelen necesitar transfusiones de sangre de manera regular, algunos pueden requerir transfusiones durante crisis hemolíticas o en situaciones de estrés. A lo largo de la vida, los pacientes pueden desarrollar esplenomegalia, hepatomegalia (agrandamiento del bazo y del hígado), y pueden tener un mayor riesgo de sobrecarga de hierro debido a la transfusión ocasional.
El diagnóstico de beta-talasemia intermedia debe diferenciarse de otras formas de anemia microcítica. Los hallazgos en el frotis sanguíneo, la electroforesis de hemoglobina y los test genéticos son fundamentales para distinguir la beta-talasemia intermedia de otras causas de anemia microcítica, como la deficiencia de hierro o anemia por enfermedad crónica.
Beta-talasemia mayor (Beta-thalassemia major)
La beta-talasemia mayor es la forma más grave de beta-talasemia, y se caracteriza por anemia severa que, sin tratamiento transfusional, puede llevar a hematocritos inferiores al 10%. Esta enfermedad resulta de mutaciones graves en ambos genes de la globina beta, lo que causa una ausencia casi total de la producción de hemoglobina A. Como consecuencia, los pacientes dependen de transfusiones de sangre regulares para sobrevivir. La sintomatología es grave y se presenta en la infancia, después de los 6 meses de edad, cuando la hemoglobina fetal (hemoglobina F) comienza a disminuir y la hemoglobina A debería ser la predominante.
- Hemoglobina y hematocrito:
- La anemia es severa, y el hematocrito puede caer a menos del 10% sin transfusiones, lo que refleja una grave deficiencia de hemoglobina.
- Volumen corpuscular medio (MCV):
- El MCV está bajo, típicamente en el rango de 55 fL a 70 fL, reflejando una microcitosis severa.
- Recuento de glóbulos rojos (RBC):
- El recuento de glóbulos rojos es normal o elevado, debido a la hiperplasia eritroide en la médula ósea que intenta compensar la anemia mediante la producción aumentada de glóbulos rojos, aunque estos son de mala calidad y son destruidos prematuramente.
- Conteo de reticulocitos:
- El conteo de reticulocitos puede estar elevado, indicando una respuesta de la médula ósea a la anemia severa. Sin embargo, esta respuesta no es suficiente para prevenir la destrucción de glóbulos rojos debido a la ineficaz eritropoyesis.
- Frotis sanguíneo periférico:
- El frotis sanguíneo es bastante anormal, mostrando características típicas de la beta-talasemia mayor, tales como:
- Poiquilocitosis severa: La presencia de glóbulos rojos de formas anormales y variadas, lo que indica la inestabilidad y la destrucción prematura de los glóbulos rojos.
- Hipocromía: Los glóbulos rojos tienen una coloración pálida debido a la falta de hemoglobina.
- Microcitosis: Los glóbulos rojos son más pequeños de lo normal.
- Células en diana (target cells): Estas células tienen una distribución anómala de hemoglobina que les da una apariencia característica.
- Estippling basofílico: La presencia de gránulos basofílicos en los glóbulos rojos, debido a la retención de ribosomas.
- Glóbulos rojos nucleados: La presencia de glóbulos rojos inmaduros con núcleo, lo que indica una producción inmadura de glóbulos rojos.
- El frotis sanguíneo es bastante anormal, mostrando características típicas de la beta-talasemia mayor, tales como:
- Electroforesis de hemoglobina:
- En la electroforesis de hemoglobina, los resultados característicos incluyen:
- Ausencia de hemoglobina A: La hemoglobina A (α₂β₂) está prácticamente ausente debido a la falta de producción de cadenas beta.
- Elevación de hemoglobina A2: Se observa una cantidad variable de hemoglobina A2 (α₂δ₂), que generalmente se encuentra en concentraciones más altas de lo normal, pero no suficiente para compensar la falta de hemoglobina A.
- Predominio de hemoglobina F: La hemoglobina fetal (hemoglobina F, α₂γ₂) es la hemoglobina predominante en estos pacientes, con niveles que pueden superar el 90% de la hemoglobina total. La hemoglobina F es compensatoria en la ausencia de hemoglobina A, aunque no es suficiente para evitar la anemia grave.
- En la electroforesis de hemoglobina, los resultados característicos incluyen:
La beta-talasemia mayor se caracteriza por una anemia grave con hematocrito menor al 10% sin transfusiones. Los hallazgos de laboratorio incluyen microcitosis, hipocromía, poiquilocitosis severa, células en diana, estippling basofílico y glóbulos rojos nucleados en el frotis sanguíneo. En la electroforesis de hemoglobina, la hemoglobina F predomina, mientras que la hemoglobina A está ausente, y se puede observar una elevación de hemoglobina A2. Los pacientes requieren transfusiones de sangre regulares para sobrevivir, ya que la anemia es muy severa. Sin tratamiento, la sobre carga de hierro debido a las transfusiones frecuentes puede provocar complicaciones graves, como insuficiencia cardíaca, arritmias, cirrosis y endocrinopatías.
El tratamiento para la beta-talasemia mayor incluye transfusiones de sangre regulares para mantener niveles adecuados de hemoglobina. A largo plazo, los pacientes pueden desarrollar sobrecarga de hierro, lo que requiere el uso de quelantes de hierro para prevenir los efectos tóxicos del hierro acumulado. En algunos casos, el trasplante de células madre hematopoyéticas puede ofrecer una opción curativa, especialmente en pacientes más jóvenes.
Diagnóstico diferencial
Las formas leves de talasemia a menudo deben diferenciarse de la anemia por deficiencia de hierro, ya que ambas pueden presentar una anemia microcítica (glóbulos rojos pequeños) y hipocrómica (glóbulos rojos pálidos). Sin embargo, existen varios puntos clave en los resultados de laboratorio que permiten hacer esta distinción de manera más precisa.
Una de las diferencias más notables es el volumen corpuscular medio (MCV). En los pacientes con talasemia, este valor suele ser más bajo que en la anemia por deficiencia de hierro, y la microcitosis tiende a ser más pronunciada. Mientras que en la deficiencia de hierro el MCV puede estar entre 70 y 75 fL, en la talasemia los valores suelen ser aún menores, a veces por debajo de 60 fL. Esta diferencia refleja una reducción más pronunciada en el tamaño de los glóbulos rojos en la talasemia.
Otro aspecto fundamental es el recuento de glóbulos rojos. En la anemia por deficiencia de hierro, el número de glóbulos rojos suele estar disminuido, ya que la médula ósea no tiene suficiente hierro para producir glóbulos rojos sanos. En cambio, en la talasemia, aunque la anemia esté presente, la médula ósea responde produciendo más glóbulos rojos, aunque estos son anormales. Por ello, en la talasemia el recuento de glóbulos rojos suele estar normal o elevado.
En cuanto al frotis sanguíneo, una de las principales herramientas para diferenciar ambas condiciones, en la talasemia se observan anomalías más marcadas en comparación con la deficiencia de hierro, incluso cuando la anemia es leve. El frotis de un paciente con talasemia muestra glóbulos rojos muy pequeños y pálidos, muchas veces en forma de células en diana (con un área de color más claro en el centro), y también se pueden ver acantocitos (glóbulos rojos con espículas irregulares). Además, en la talasemia se observa poiquilocitosis (formas de glóbulos rojos anormales) y, en casos más graves, glóbulos rojos nucleados. En cambio, en la anemia ferropénica, el frotis es más sencillo y no presenta estos hallazgos tan característicos.
La reticulocitosis, es decir, un aumento en los glóbulos rojos inmaduros, es otro factor importante. En la talasemia, debido a la hemólisis crónica (destrucción prematura de los glóbulos rojos) y la eritropoyesis ineficaz (producción defectuosa de glóbulos rojos en la médula ósea), se genera una respuesta compensatoria, lo que resulta en un aumento de los reticulocitos. En la anemia ferropénica, esta respuesta suele ser menos pronunciada, salvo en casos graves de deficiencia de hierro.
Cuando se realizan los estudios de hierro, los resultados también marcan una diferencia importante. En la anemia por deficiencia de hierro, los niveles de ferritina (que refleja las reservas de hierro en el cuerpo) y la saturación de transferrina suelen estar bajos. Esto indica que el cuerpo no tiene suficiente hierro para producir hemoglobina. En contraste, en los pacientes con talasemia, los estudios de hierro son normales o elevados, porque la destrucción de los glóbulos rojos defectuosos libera hierro al torrente sanguíneo, lo que puede llevar a una sobrecarga de hierro.
En cuanto al diagnóstico de las diferentes formas de talasemia, la beta-talasemia puede diagnosticarse fácilmente mediante electroforesis de hemoglobina, que muestra una elevación de hemoglobina A2 y hemoglobina F. Estos cambios en las hemoglobinas son una manifestación clave de la enfermedad, ya que la hemoglobina A (la principal hemoglobina adulta) está disminuida o ausente, y las hemoglobinas A2 y F sustituyen parcialmente la función de la hemoglobina A. Además, el diagnóstico definitivo de beta-talasemia puede confirmarse con análisis genético, específicamente mediante la secuenciación del gen de la globina beta.
Por otro lado, el diagnóstico de alfa-talasemia se basa más en la exclusión, ya que la electroforesis de hemoglobina no muestra cambios significativos en las proporciones de hemoglobinas normales. En estos casos, el diagnóstico se confirma mediante estudios genéticos para detectar la deleción de los genes alfa-globina.
Es importante recordar que existen otras anemias microcíticas que podrían parecerse a la talasemia, pero la característica única de la talasemia es que, en su mayoría, los pacientes presentan un recuento de glóbulos rojos normal o elevado. Esto también es cierto en el caso de la policitemia vera, una enfermedad en la que hay una proliferación excesiva de glóbulos rojos, lo que también puede generar una anemia microcítica, pero en este caso el origen es distinto y suele estar relacionado con un trastorno hematológico subyacente.
Tratamiento
El manejo de los pacientes con talasemia depende de la gravedad de la enfermedad y de las necesidades específicas de cada paciente. En los casos leves de talasemia, como la alfa-talasemia menor o la beta-talasemia menor, no es necesario un tratamiento específico. Estos pacientes generalmente no presentan síntomas graves, por lo que su principal objetivo es evitar que se les haga un diagnóstico erróneo. Es crucial que se les identifique correctamente para evitar que reciban tratamientos inadecuados, como los suplementos de hierro, que son innecesarios en la talasemia y podrían empeorar una posible sobrecarga de hierro.
En el caso de la enfermedad por hemoglobina H, que es una forma más grave de la alfa-talasemia, el tratamiento incluye suplementación con ácido fólico (1 mg por día), ya que esta vitamina es fundamental para la producción de glóbulos rojos. Además, estos pacientes deben evitar medicamentos que contienen hierro y también medicamentos oxidantes, como los sulfonamidas, que pueden causar daños adicionales a los glóbulos rojos ya comprometidos. Este tipo de enfermedad se caracteriza por una hemólisis crónica, por lo que el control adecuado es fundamental para evitar complicaciones mayores.
En los pacientes con formas graves de talasemia, como la beta-talasemia mayor (también conocida como anemia de Cooley), el tratamiento es más intensivo. Estos pacientes suelen necesitar transfusiones regulares de glóbulos rojos para mantener sus niveles de hemoglobina y evitar que la anemia empeore. Las transfusiones regulares también ayudan a suprimir la eritropoyesis endógena, es decir, la producción de glóbulos rojos por la médula ósea, lo que de otra manera podría llevar a una expansión excesiva de la médula ósea y otros problemas óseos.
Dado que las transfusiones de sangre pueden provocar una sobrecarga de hierro debido a que el cuerpo no tiene un mecanismo natural para eliminar el exceso de este mineral, los pacientes con talasemia grave deben ser tratados con quelantes de hierro. Estos medicamentos, que se administran por vía oral o parenteral, ayudan a eliminar el hierro acumulado en el cuerpo, evitando así daños en órganos vitales como el corazón, el hígado y el páncreas. Sin un tratamiento adecuado de quelación, la sobrecarga de hierro puede causar insuficiencia cardíaca, cirrosis hepática, diabetes y otras complicaciones graves.
Además, algunos pacientes pueden desarrollar hiper-esplenismo, que es cuando el bazo se agranda y elimina demasiados glóbulos rojos, lo que aumenta la necesidad de transfusiones. Si esto sucede, se puede considerar la esplenectomía, es decir, la extirpación del bazo, para reducir esta demanda.
Un avance más reciente en el tratamiento de la beta-talasemia grave es el uso de luspatercept, un medicamento aprobado por la FDA para pacientes dependientes de transfusiones. El luspatercept actúa como un trampón del ligando TGF-beta, promoviendo la maduración de los glóbulos rojos y ayudando a reducir la necesidad de transfusiones. Esto mejora significativamente la calidad de vida de los pacientes, aliviando las complicaciones relacionadas con la sobrecarga de hierro y la dependencia de transfusiones.
El trasplante de células madre hematopoyéticas alogénicas es considerado el tratamiento de elección para los niños con beta-talasemia mayor. Este tratamiento ofrece una opción curativa, especialmente cuando se realiza en etapas tempranas de la enfermedad, antes de que el paciente haya sufrido daños orgánicos significativos debido a la sobrecarga de hierro. En los niños que aún no han experimentado complicaciones por esta sobrecarga, el trasplante tiene una tasa de éxito notable, con más del 80% de los casos mostrando una supervivencia a largo plazo, lo que representa una mejora considerable en la calidad de vida y la esperanza de vida de los pacientes.
En cuanto a las alternativas terapéuticas innovadoras, actualmente se encuentra disponible la terapia génica con células madre hematopoyéticas autólogas para el tratamiento de la beta-talasemia dependiente de transfusiones. Este tratamiento utiliza betibeglogene autotemcel, que es una terapia basada en un gen betaA-T87Q modificado. En esta estrategia, las células madre hematopoyéticas del propio paciente son recolectadas, modificadas genéticamente para corregir el defecto en el gen de la hemoglobina beta, y luego reintroducidas en el cuerpo del paciente. Esta forma de terapia génica ha mostrado ser prometedora, ya que ofrece una alternativa menos invasiva al trasplante de células madre alogénicas, reduciendo los riesgos asociados con la necesidad de un donante compatible.
Ambas estrategias, el trasplante alogénico de células madre y la terapia génica autóloga, han transformado el tratamiento de la beta-talasemia mayor en los últimos años, ofreciendo a los pacientes la posibilidad de vivir sin la necesidad constante de transfusiones de sangre, lo que a su vez minimiza los riesgos relacionados con la sobrecarga de hierro y otras complicaciones de la enfermedad.

Fuente y lecturas recomendadas:
- Cappellini, M. D., et al. The use of luspatercept for thalassemia in adults. Blood Adv. 2021; 5:326. [PMID: 33570654]
- Hokland, P., et al. Thalassemia—A global view. Br J Haematol. 2023; 201:199. [PMID: 36799486]
- Horvei, P., et al. Advances in the management of α-thalassemia major: reasons to be optimistic. Hematol Am Soc Hematol Educ Program. 2021; 2021:592. [PMID: 34889445]
- Locatelli, F., et al. Betibeglogene autotemcel gene therapy for non-β0/β0 genotype β-thalassemia. N Engl J Med. 2022; 386:415. [PMID: 34891223]
- Taher, A. T., et al. β-Thalassemias. N Engl J Med. 2021; 384:727. [PMID: 33626255]